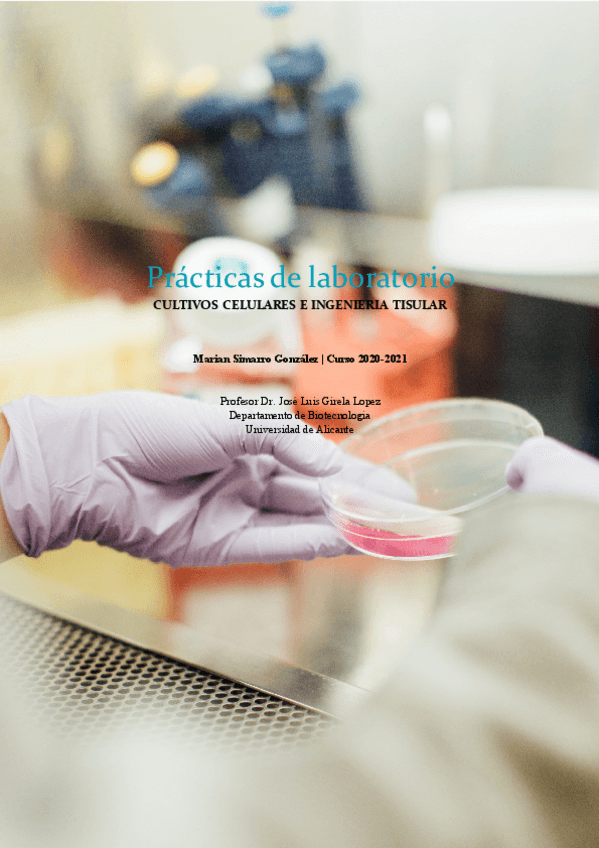

@msg123
174 Publicaciones
4.94k Interacciones
4 Seguidores
0 Siguiendo
Lista de publicaciones de msg123
ejercicios
-
Ejercicios GEN y BQ 2021
He publicado nuevos ejercicios de 3º Técnicas Moleculares: Ejercicios GEN y BQ 2021
He publicado nuevos trabajos de 4º CULTIVOS CELULARES E INGENIERÍA TISULAR: Practicas-de-laboratorio.pdf
apuntes
-
Por bloques
He publicado nuevos apuntes de 4º CULTIVOS CELULARES E INGENIERÍA TISULAR: Por bloques
He publicado nuevos ejercicios de 4º BIOTECNOLOGÍA ENZIMÁTICA E INGENIERÍA METABÓLICA: Problemas-BEIM.pdf
practicas
-
CORREGIDOS Informes PL y PO
He publicado nuevos practicas de 4º BIOTECNOLOGÍA ENZIMÁTICA E INGENIERÍA METABÓLICA: CORREGIDOS Informes PL y PO
He publicado nuevos ejercicios de 2º FISIOLOGÍA VEGETAL: NUTRICIÓN, TRANSPORTE Y METABOLISMO: PROBLEMAS-resueltos.pdf
He publicado nuevos practicas de 3º Fisiología del Desarrollo Vegetal: HernandezRomero-SimarroGonzalez.pdf
ejercicios
-
CP CORREGIDOS
He publicado nuevos ejercicios de 2º Ecología: CP CORREGIDOS
He publicado nuevos trabajos de 2º Ecología: Produccion-secundaria.pdf
He publicado nuevos trabajos de 2º Fisiologia Animal I: poster-revisar.pdf
apuntes
-
Comision apuntes 19-20
He publicado nuevos apuntes de 3º Fisiología Animal II: Comision apuntes 19-20